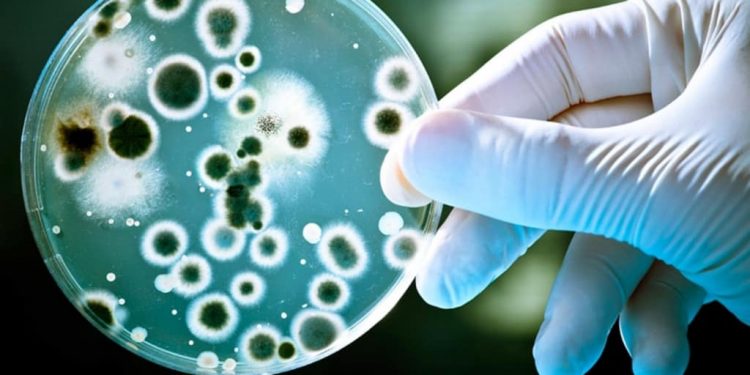
Бруцеллезден сақтаныңыз!

Бруцеллез – малдан адамға жұғатын жұқпалы ауру, көп жағдайда созылмалы түрде кездесіп, бірнеше уақыттан соң ауруы қайта қозу немесе қайталану жағдайлары жиі кездеседі.
Бруцеллез ауруының негізгі клиникалық көрінісі: дене қызуының ұзақ уақыт бойы көтерілуі, буын-сүйек сырқырауы, нерв-жүйке, жүрек-тамыр, зәр шығару, жыныс ағзалары және т.б. жүйелердің аллергиялық әрекеттің әсерінен қызметтері бұзылады.
Бруцеллез ауруы бруцелла микробымен шақырылады, ауру қоздырғышы жарақатталмаған тері арқылы да адам ағзасына енуге бейім, аса жоғарғы жұқтырғыш қасиетімен ерекшелінеді.
Бруцеллез ауруының негізгі жұқтырушы көзі: қой, ешкі, ірі қара мал және шошқалар болып табылады. Бруцеллез ауруы майда малдар арасында жиі кездеседі. Жануарлар ауруды жем, су, көң, тезек арқылы жұқтырады, ал адамдар болса ауру малды күтіп-қарауда, әсіресе төлдеу кезінде, мал сою және бөлшектеу кезінде, мал өнімдері және шикі затымен айналысқанда, тағамға ауру малдың сүтін, сүт өнімдерін және етін қолданғанда және ауру мал жүндерін өңдегенде, мал тұрған, төлдеген орындарды көңнен тазалау кезінде ұшқан шаң-тозаң арқылы жұғуы мүмкін.
Сондықтан аурудың алдын алудың ең бір маңыздысы жеке бас гигиенасын сақтау болып табылады. Малмен және оның өнімдерімен жұмыс істегенде арнайы киіммен, қолғаппен жұмыс істеген абзал. Қол жарақаттары болса жақсылап танып қою керек. Жұмыс істеп болғаннан кейін қолды жуу, киімді ауыстыру сияқты іс-әрекеттер аурудың алдын алады. Етті, сүтті шикідей жеу өте қауіпті, оларды тек қайнатып, пісірген соң тұтыну қажет екенін есте ұстаңыздар.
Үйдегі малдарды ветеринар мамандарға тексертіп отыру, ауру мал анықталса, сау малдардан оқшаулап, жою қажет. Мал орындарын залалсыздандырып, тазалау керек. Ет, сүт өнімдерін тексеруден өткен, анықтамасы бар арнайы дүкендерден сатып алуларыңыз қажет.
Жоғарыда аталған белгілер пайда болса, тез арада дәрігерге көрініп, ем алғаныңыз жөн.
Ең бастысы қандай да ауру болмасын оны алдын алған дұрыс!
Нышанов Нұрбек Садықбекұлы
ҚР ДСМ СЭБК Түркістан облысының санитариялық-эпидемиологиялық бақылау департаменті басшысы